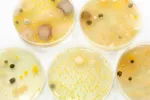

Prevención de intoxicaciones alimentarias

Actualizado: 22 de septiembre de 2022
En la mayoría de ocasiones está en nuestra mano el poder evitar una intoxicación alimentaria. Según la Organización Mundial de la Salud, la población debe tener en cuenta cinco claves para garantizar la seguridad de los alimentos que van a consumir:
-

Extremar la higiene
-

Separar los alimentos crudos de los cocinados
-

Cocinar completamente los alimentos
-

Conservar los alimentos a temperaturas adecuadas
¿Qué se debe hacer con los alimentos congelados?
¿Por qué se debe hacer?
-

Usar agua y alimentos seguros
Creado: 12 de enero de 2011